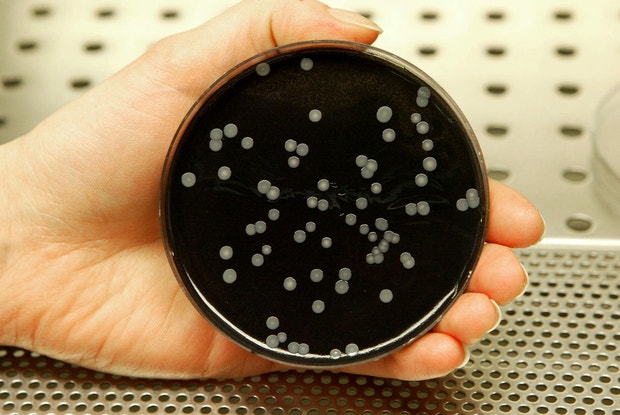

Dia 7 de novembro de 2014: o concelho de Vila Franca de Xira vive um dos maiores surtos de legionella de sempre, que chega a ser considerado o segundo mais grave à escala mundial.
De acordo com o Centro Europeu de Prevenção e
Controlo de Doenças (ECDC), no topo da lista está um surto no Reino
Unido, em 2002, com 494 infetados e sete mortos.
No total, o Ministério Público recebeu 209 queixas-crime e, neste momento, ainda decorre o inquérito no Departamento de Investigação e Ação Penal. A coberto do segredo de justiça.
“O inquérito encontra-se em investigação e está em segredo de justiça. O número de queixas é de 209. Foram apresentadas em nome individual e juntas ao processo instaurado oportunamente pelo Ministério Público”, adiantou ao site da RTP a Procuradoria-Geral da República.
Quase um ano depois de o surto de legionella ter acontecido, a Polícia Judiciária está ainda a interrogar testemunhas. Fonte ligada à investigação disse à RTP que o processo está “relativamente adiantado”, mas não foi possível apurar o teor dos interrogatórios, tão-pouco as pessoas que estão a ser ouvidas.
Mandados emitidos para cinco empresas
Na altura, cinco empresas de Vila Franca de Xira - Adubos de Portugal, Central de Cervejas, Dan Cake, Grief e Solvay - foram alvos de mandados da Inspeção-Geral do Ambiente e do Ordenamento do Território (IGAOT), tendo sido obrigadas a parar a laboração.
O relatório final da Direção Geral de Saúde com a data de 21 de novembro de 2014 refere que "serão enviados ao Ministério Público, os relatórios até agora produzidos bem como os relatórios da sequenciação do genoma para eventual apuramento de crime ambiental com origem na água de uma das torres de refrigeração da empresa Adubos de Portugal (ADP)".
A RTP contactou esta sexta-feira a empresa Adubos de Portugal, que remeteu para mais tarde eventuais declarações, por escrito, sobre o processo.
No dia 9 de novembro de 2014, “com base no princípio da precaução, decidiu-semandar suspender o funcionamento das torres de arrefecimento das unidades fabris locais tidas como suspeitas de serem fontes de contaminação, por terem revelado resultados positivos para a legionella nas amostras recolhidas pelas autoridades de saúde”, pode ler-se no documento.
O relatório final da Direção Geral de Saúde com a data de 21 de novembro de 2014 refere que "serão enviados ao Ministério Público, os relatórios até agora produzidos bem como os relatórios da sequenciação do genoma para eventual apuramento de crime ambiental com origem na água de uma das torres de refrigeração da empresa Adubos de Portugal (ADP)".
A RTP contactou esta sexta-feira a empresa Adubos de Portugal, que remeteu para mais tarde eventuais declarações, por escrito, sobre o processo.
No dia 9 de novembro de 2014, “com base no princípio da precaução, decidiu-semandar suspender o funcionamento das torres de arrefecimento das unidades fabris locais tidas como suspeitas de serem fontes de contaminação, por terem revelado resultados positivos para a legionella nas amostras recolhidas pelas autoridades de saúde”, pode ler-se no documento.
Nalguns casos, as amostras recolhidas acabaram por não confirmar a presença de legionella, noutros as empresas cumpriram os requisitos definidos para o levantamento dos mandados, que incluíam a limpeza e desinfeção das torres de arrefecimento e a comprovação, através de análises realizadas por laboratório independente reconhecido.
De acordo com outro dos relatórios sobre o surto de legionella (para publicação numa revista internacional), datado de 15 de dezembro de 2014, tinham sido registados 375 casos de doença e 12 óbitos. O site da RTP obteve agora a informação de que esses números aumentaram ligeiramente, tendo afinal sido registados 14 óbitos e 403 casos de doença. Os números foram divulgados à reportagem da RTP pela Direção-Geral da Saúde (DGS).
Também nesse relatório é referido que "ficou demonstrada a correspondência da estirpe de bactérias isoladas numa das torres de arrefecimento de uma unidade fabril local [Adubos de Portugal] com a estirpe identificada em secreções brônquicas de doentes".
"Estamos perante resultados que resultam de análises de cultura e uma coincidência com a estirpe clínica", disse na altura o ministro do Ambiente, Ordenamento do Território e Energia, Jorge Moreira da Silva.
O governante disse ainda que os dados, que confirmavam a semelhança da bactéria encontrada na torre de arrefecimento da Adubos de Portugal e aquela que provocou a infeção de centenas de doentes, seriam enviados para o Ministério Público, “entidade responsável por determinar se na realidade estamos, ou não, perante um caso de crime ambiental”.Medo e revolta entre a população
As freguesias de Forte da Casa, Póvoa de Santa Iria e Vialonga, as mais afetadas pelo surto, foram regressando à normalidade. Mas a vida nunca mais foi a mesma.
Ninguém se esquece de quem perdeu ali a vida, das pessoas que ficaram com sequelas, que ainda hoje têm de recorrer aos hospitais e que se cansam ao andarem meia dúzia de metros.
Porta sim porta não, encontramos alguém que teve legionella. Maria, Mena, Irene e Rosa sobreviveram.
Maria Isabel Raimundo tem 65 anos, vive na Granja, em Vialonga, e trabalhava na Praça de Cabo de Vialonga. Esteve 16 dias internada, mas nunca mais foi trabalhar.
“Nunca mais fui trabalhar. A minha médica disse-me para eu me deixar disso porque tinha que fazer força. Eu vendia fruta e hortaliça na praça. Tinha que fazer muita força para carregar as caixas e aquilo é muito frio”, disse quase conformada ao site da RTP.
E acrescenta: “Se faço alguma coisa, tenho sempre uma pontada nas costas. O médico diz que isto é normal e pronto. Coitado de quem teve o mal e de quem ficou desgraçado. Nós ficámos a sofrer”.
Mena Fernandes, proprietária de uma pastelaria em Forte da Casa, não foi afetada pelo surto, mas nem sabe como escapou. A palavra que mais ouve no seu estabelecimento comercial é medo, logo seguida de revolta.
“Tem que haver responsáveis pelas pessoas que estão afetadas e eu deixo uma pergunta no ar: quem não foi afetado mas que respirou o mesmo ar, que consequências pode vir a ter? As pessoas continuam com muito medo. Está-se a aproximar a data em que tudo aconteceu, a altura do frio e as pessoas têm medo”.
Em novembro do ano passado, a população do concelho de Vila Franca de Xira viveu dias dramáticos. Irene Alegre, de Forte da Casa, com 64 anos de idade, disse à RTP que nunca mais foi a mesma pessoa.
“Desde que tive legionella, sinto que não sou a mesma pessoa porque estou muito bem e, de repente, dá-me uma fraqueza esquisita que me faz ir para a cama”.
"Quem fez o crime tem que pagar"
Irene esteve entre aqueles que avançaram com uma queixa-crime. Todavia, as esperanças são curtas: “Se quer que lhe diga não tenho esperanças nenhumas porque anda tudo tão calado, tão sossegado, que não espero nada. Quem fez o crime tem que pagar”.
Na Póvoa de Santa Iria o cenário não muda muito. Fomos falar com Maria Rosa, outra das pessoas infetadas com legionella. Depois do surto, já foi internada mais duas vezes com pneumonia.
“Já estive internada mais duas vezes com pneumonia porque uma simples corrente de ar que eu apanhe provoca-me logo pneumonia. Tenho que ter muito cuidado com as mudanças de temperatura”.
Rosa desistiu de apresentar queixa-crime porque não tinha dinheiro para avançar, já que a autarquia de Vila Franca de Xira apenas deu apoio judiciário.
“Desisti porque achei que não valia a pena. Tinha que arranjar advogado. A saúde que eu tinha já ninguém me a vai dar, o dinheiro também não me vai fazer feliz por isso. Era feliz era se ficasse bem e estivesse com saúde”.
Ninguém se esquece de quem perdeu ali a vida, das pessoas que ficaram com sequelas, que ainda hoje têm de recorrer aos hospitais e que se cansam ao andarem meia dúzia de metros.
Porta sim porta não, encontramos alguém que teve legionella. Maria, Mena, Irene e Rosa sobreviveram.
Maria Isabel Raimundo tem 65 anos, vive na Granja, em Vialonga, e trabalhava na Praça de Cabo de Vialonga. Esteve 16 dias internada, mas nunca mais foi trabalhar.
“Nunca mais fui trabalhar. A minha médica disse-me para eu me deixar disso porque tinha que fazer força. Eu vendia fruta e hortaliça na praça. Tinha que fazer muita força para carregar as caixas e aquilo é muito frio”, disse quase conformada ao site da RTP.
E acrescenta: “Se faço alguma coisa, tenho sempre uma pontada nas costas. O médico diz que isto é normal e pronto. Coitado de quem teve o mal e de quem ficou desgraçado. Nós ficámos a sofrer”.
Mena Fernandes, proprietária de uma pastelaria em Forte da Casa, não foi afetada pelo surto, mas nem sabe como escapou. A palavra que mais ouve no seu estabelecimento comercial é medo, logo seguida de revolta.
“Tem que haver responsáveis pelas pessoas que estão afetadas e eu deixo uma pergunta no ar: quem não foi afetado mas que respirou o mesmo ar, que consequências pode vir a ter? As pessoas continuam com muito medo. Está-se a aproximar a data em que tudo aconteceu, a altura do frio e as pessoas têm medo”.
Em novembro do ano passado, a população do concelho de Vila Franca de Xira viveu dias dramáticos. Irene Alegre, de Forte da Casa, com 64 anos de idade, disse à RTP que nunca mais foi a mesma pessoa.
“Desde que tive legionella, sinto que não sou a mesma pessoa porque estou muito bem e, de repente, dá-me uma fraqueza esquisita que me faz ir para a cama”.
"Quem fez o crime tem que pagar"
Irene esteve entre aqueles que avançaram com uma queixa-crime. Todavia, as esperanças são curtas: “Se quer que lhe diga não tenho esperanças nenhumas porque anda tudo tão calado, tão sossegado, que não espero nada. Quem fez o crime tem que pagar”.
Na Póvoa de Santa Iria o cenário não muda muito. Fomos falar com Maria Rosa, outra das pessoas infetadas com legionella. Depois do surto, já foi internada mais duas vezes com pneumonia.
“Já estive internada mais duas vezes com pneumonia porque uma simples corrente de ar que eu apanhe provoca-me logo pneumonia. Tenho que ter muito cuidado com as mudanças de temperatura”.
Rosa desistiu de apresentar queixa-crime porque não tinha dinheiro para avançar, já que a autarquia de Vila Franca de Xira apenas deu apoio judiciário.
“Desisti porque achei que não valia a pena. Tinha que arranjar advogado. A saúde que eu tinha já ninguém me a vai dar, o dinheiro também não me vai fazer feliz por isso. Era feliz era se ficasse bem e estivesse com saúde”.
Relatórios enviados à justiça
Contactado pelo site da RTP, Francisco George, diretor da DGS, disse que entregaram “os relatórios à justiça e
agora é na justiça, mediante as comprovações laboratoriais que foram
entregues, que compete perceber e decidir se há ou não há indícios para o
caso ser julgado”.
“Foi uma situação gravíssima, a segunda maior de sempre na história da doença dos legionários em todo o mundo, mas foi possível perceber qual era o problema e descobrir num tempo muito rápido qual era a fonte da infeção e encontrar uma explicação para terem surgido de forma explosiva mais de 400 casos de pneumonias graves”, frisou Francisco George.
Quanto à morosidade do processo, o diretor da DGS disse que “o que não seria normal era nós ainda estarmos às escuras sem ter percebido a fonte da infeção. A DGS ocupou-se unicamente da identificação rápida do problema e do seu controle. Nada mais interessa em termos de competências à DGS. Outros órgãos de soberania, nomeadamente, os tribunais, tratam das questões de responsabilidade”.
“Foi uma situação gravíssima, a segunda maior de sempre na história da doença dos legionários em todo o mundo, mas foi possível perceber qual era o problema e descobrir num tempo muito rápido qual era a fonte da infeção e encontrar uma explicação para terem surgido de forma explosiva mais de 400 casos de pneumonias graves”, frisou Francisco George.
Quanto à morosidade do processo, o diretor da DGS disse que “o que não seria normal era nós ainda estarmos às escuras sem ter percebido a fonte da infeção. A DGS ocupou-se unicamente da identificação rápida do problema e do seu controle. Nada mais interessa em termos de competências à DGS. Outros órgãos de soberania, nomeadamente, os tribunais, tratam das questões de responsabilidade”.
Francisco George salientou ainda a rapidez e eficácia com que o surto foi tratado, com a participação de uma vasta equipa de médicos e profissionais em saúde pública.
“Foi resultado desse trabalho articulado, harmonioso, coletivo, de reflexão, que rapidamente se conseguiu identificar a fonte da infeção e uma vez encerrada, naturalmente, que os casos acabaram, terminaram. Tratou-se de uma intervenção, reconhecidamente, eficaz”, salientou o director da DGS.
Segundo o mesmo documento, datado de 15 de dezembro de 2014, o último que foi dado a conhecer, a idade média das pessoas afetadas pelo surto foi de 58 anos, com uma amplitude de variação entre os 22 e os 92 anos de idade.
Do total dos casos notificados, 78 por cento dos doentes residiam no concelho de Vila Franca de Xira, 11 por cento no concelho de Loures e 11 por cento habitavam noutras freguesias. Todos os casos identificados tiveram ligação epidemiológica (residência, trabalho, permanência ou deslocação) ao concelho de Vila Franca de Xira ou freguesias limítrofes de outros municípios.
O surto, considerado de grandes dimensões pela sua magnitude, foi controlado em duas semanas. “O período de duração do surto de Vila Franca de Xira, uma vez avaliados os casos retrospetivamente, com base na data de início de sintomas, foi estimado entre os dias 12 de outubro e 4 de dezembro”, diz o mesmo relatório.
E acrescenta que “foram remetidos ao Ministério Público os elementos que poderão eventualmente consubstanciar a prática de um crime de poluição, encontrando-se o processo em segredo de justiça”.
Autarquia pondera interpor ação
A Câmara Municipal de Vila Franca de Xira quis dar a possibilidade de acesso à justiça, a quem foi de alguma forma afetado.
"Para isso, no início de 2015 estabeleceu um protocolo com a delegação de Vila Franca de Xira da Ordem dos Advogados para aconselhamento jurídico. Para o efeito, e gratuitamente, disponibilizaram-se cerca de 30 advogados que atenderam perto de 200 pessoas, parte das quais apresentaram queixas-crime no Ministério Público", disse ao site da RTP a autarquia.
"Para isso, no início de 2015 estabeleceu um protocolo com a delegação de Vila Franca de Xira da Ordem dos Advogados para aconselhamento jurídico. Para o efeito, e gratuitamente, disponibilizaram-se cerca de 30 advogados que atenderam perto de 200 pessoas, parte das quais apresentaram queixas-crime no Ministério Público", disse ao site da RTP a autarquia.
O município não descarta ainda a possibilidade de interpor também uma ação em Tribunal, "mediante a acusação que vier a ser deduzida, a fim de ser ressarcido pelos danos de que o concelho foi alvo".
Na nota enviada por email à RTP, a autarquia diz ainda que se trata "de uma averiguação complexa, no entanto, é necessário, por respeito às vítimas, que a justiça conclua rapidamente este processo. Por outro lado, este grave acontecimento de saúde pública deve exigir das respetivas entidades um reforço da prevenção e avaliação regular de potenciais agentes de poluição, de modo a evitar um novo caso como este".
"Nada foi tornado público"
Na nota enviada por email à RTP, a autarquia diz ainda que se trata "de uma averiguação complexa, no entanto, é necessário, por respeito às vítimas, que a justiça conclua rapidamente este processo. Por outro lado, este grave acontecimento de saúde pública deve exigir das respetivas entidades um reforço da prevenção e avaliação regular de potenciais agentes de poluição, de modo a evitar um novo caso como este".
"Nada foi tornado público"
Jorge Ribeiro, presidente da União das Freguesias da Póvoa de Santa Iria e Forte da Casa, salientou ao site da RTP a importância, para a população, de saber quem foram os culpados pelo surto de legionella.
“Nós temos que lamentar que vivamos num país onde nós acusamos primeiro ou não conseguimos provar ou então as coisas demoram meses e anos a fio até que haja alguma conclusão ou que se encontrem responsáveis sobre as situações que aconteceram. No nosso caso em concreto, e com a gravidade daquilo que se passou aqui na freguesia e no concelho, lamentamos naturalmente que quase um ano depois continuamos praticamente na linha de partida, tanto quanto sabemos é um processo que está em segredo de justiça mas até à data ainda não se conseguiu apurar os responsáveis daquilo que aconteceu”, lamenta Jorge Ribeiro.
O autarca disse ainda que “alegadamente haveria responsáveis, mas até à data nunca foi possível apurar ou provar porque um ano depois nada foi tornado público. Não temos conhecimento de nenhum desenvolvimento do processo e, portanto, aquilo que me leva a crer é que das duas uma, ou aquilo que foi dito na altura não correspondia à verdade ou então provavelmente as entidades que estão a investigar a situação saberão mais do que aquilo que é conhecido publicamente. Temos que lamentar efetivamente”.
"Queremos saber"
Jorge Ribeiro espera que o apuramento da verdade seja feito o mais rapidamente possível com a Polícia Judiciária, o Ministério Público, as agências ambientais e todas as entidades que estão no terreno, no sentido de que a situação não volte a repetir-se.
Sobre o facto que a RTP apurou, de ainda haver pessoas inquiridas pela Judiciária, o autarca responde: “Naturalmente, acho estranho porque estas coisas têm que ser rápidas, têm que ser céleres, e portanto, não podemos andar anos a investigar coisas que à partida, na altura, já se sabia qual era a origem”.
“Nós temos que perceber aquilo que se passou. É fundamental. E não vai ser a Junta de Freguesia, não vão ser os munícipes que vão procurar respostas sobre isto. Por isso é que nós temos um Estado organizado, com um conjunto de instituições, com gente especializada para investigar estas coisas. Estranho que um ano depois, à partida, tendo em conta aquilo que sabemos, estamos praticamente na mesma e até à data não temos nenhuma informação. Se há novas informações nós também gostaríamos de saber, até para podermos descansar a população”, frisou o autarca.
 "Assumir causas como absolutas"
"Assumir causas como absolutas"“Às vezes a justiça tem abordagens diferentes das abordagens dos epidemiologistas na noção de casualidade e isso implica, frequentemente, uma abordagem diferente destas questões. Geralmente os sistemas judiciais têm uma concepção de casualidade assumindo as causas como absolutas, isto é, tem que se provar com absoluta certeza que A causou B, enquanto a epidemiologia diz que há noções muito mais probabilísticas, isto é, com os dados evidenciados há uma enorme probabilidade de X por cento de que A tenha causado B”, explicou ao site da RTP Guilherme Gonçalves, professor no Instituto Abel Salazar do Porto, médico de saúde pública, epidemiologista e autor de diversos artigos científicos sobre legionella publicados em revistas internacionais.
O especialista adiantou ainda que o preocupa o facto de, às vezes, o sistema judicial lidar mal com esta abordagem probabilística: “Como cidadão isso preocupa-me. Isto é, se eu disser que há 999 hipóteses em 1000 de que A tenha causado B, eu imagino que o advogado vai passar o tempo a falar de uma entre 1000, de que A não tenha provocado B. Eu não sei se é deste caso que estou a falar, mas essa é uma questão a por ao Ministério da Justiça, tal como a morosidade dos casos”.
Sobre Vila Franca de Xira, Guilherme Gonçalves adiantou que, como epidemiologista, não conhece o caso, “mas se me disser que, por exemplo, o senhor António, residente na cidade A, adoeceu com legionella com uma bactéria que é precisamente a mesma de uma torre de arrefecimento de uma unidade industrial, perto da sua habitação, isso é claríssimo como a água. A fonte de contaminação foi naquela unidade industrial”.
Este médico e professor confessou à RTP que está “curioso” com o desfecho do processo. “Se houve uma entidade responsável por uma epidemia de tal gravidade, com mortes, e que escapa à ação judicial, isso preocupa-me enquanto cidadão. Eu gostaria que o meu país tivesse leis e instituições que permitam responsabilizar civil e criminalmente entidades e pessoas que estejam na base de uma coisa com esta gravidade”.
"Tudo corre bem se ninguém morrer"
Ainda assim, o especialista realçou que num país que tem “felizmente muitas fábricas e emprega milhares de pessoas, quando acontece um problema culpam-se as entidades fiscalizadoras, que não têm meios para fiscalizar aquelas indústrias todas, muito menos 24 horas por dia, nem poderes divinos de adivinhação para saber quando é que vai acontecer o problema”.
Para este médico, a existência de entidades fiscalizadoras “não deve criar buracos na legislação, que permitam às entidades que fazem as coisas lavar as mãos quando há problemas. Deve haver centenas de instalações em Portugal com péssimos programas de manutenção, mas tudo corre bem se não houver ninguém a morrer nem a adoecer. Até um dia”.
 Obrigatoriedade torna-se recomendação
Obrigatoriedade torna-se recomendaçãoEm agosto de 2013, a lei relativa à qualidade do ar interior foi alterada. De acordo com a Associação Portuguesa de Indústria de Refrigeração e Ar Condicionado (APIRAC), esta alteração teve um impacto enorme, já que a manutenção dos sistemas e da qualidade do ar deixou de ser obrigatória na maior parte dos edifícios e as inspeções obrigatórias aos equipamentos passaram a recomendações.
“A saúde pública saiu altamente prejudicada, dado terminarem as certificações de QAI (Análises de Qualidade do Ar Interior) que constituíam um verdadeiro rastreio de todo o tipo de poluentes no interior dos edifícios”, disse Fernando Brito, presidente da APIRAC.
Além disso veio condicionar o desemprego, já que “centenas de engenheiros investiram milhares de euros na sua qualificação, certificação e reconhecimento para o exercício legal de peritos qualificados”.
A juntar a estes dois fatores, a APIRAC disse ao site da RTP que houve desprestígio internacional, já que “fomos o primeiro país a implementar esta certificação, muito elogiada por outros países que a tomaram como exemplo para alteração da sua legislação interna. Agora voltamos para a cauda do processo”.
Para Fernando Brito deixou de haver uma intervenção preventiva de sensibilização-retificação, “que era regulamentarmente obrigatória e de difícil fuga, para passar a uma punitiva, isto é, quando morrem pessoas pune-se o responsável (quando se encontra)”.
"Só se atua após denúncia ou acidente grave"
De acordo com esta associação, as certificações terminaram, mas a obrigação de cumprir os parâmetros legais não. Pelo contrário, “passou a ser mais exigente, mais cara e muito menos efetiva. Anteriormente, existiam centenas de peritos que verificavam centenas de edifícios por ano, agora só se atua, genericamente, após denúncia ou acidente grave.
“Relativamente às inspeções dos equipamentos (que é obrigatória, embora tenha uma cláusula de substituição de difícil implementação), parece ser certo que a sua não existência constitui um dos pontos (entre outros) que, enquanto não forem corrigidos na lei portuguesa, justificam a retenção, a nível da Comissão Europeia, das verbas de financiamento para a recuperação energética dos edifícios, nomeadamente no plano da reabilitação urbana, por incumprimento da diretiva europeia”, sublinhou o presidente da APIRAC.

Poupança não pode ameaçar qualidade
Questionado sobre se a poupança energética está a pôr em causa a qualidade do ar no interior dos edifícios, Fernando Brito disse que pode acontecer, mas não necessariamente.
“A grande vantagem da lei anterior era a de que havia sempre um perito que era simultaneamente responsável pelas duas vertentes, tendo portanto que encontrar os equilíbrios necessários. Aliás, a diretiva é muito clara em esclarecer que a poupança energética não pode pôr em risco a qualidade do ar interior, só que deixou de haver responsável por esse equilíbrio e verificações periódicas que o equacionassem”.
O presidente da APIRAC acredita que há grandes edifícios privados e públicos que fecham os registos do ar novo exterior ou param os ventiladores para poupar energia, pondo em risco a saúde dos utilizadores, e provocando graus de absentismo de custo muito superior a essa poupança.
Quanto ao surto de legionella que afetou o concelho de Vila Franca de Xira, Fernando Brito classificou a situação de muito grave, dizendo que aconteceu por falta de ações de prevenção e de legislação não regulamentada e pouco precisa.
“Embora o caso se desse em instalações industriais, é verdade que o problema também pode afetar grandes edifícios específicos de comércio e serviços, exatamente com o mesmo agente patológico e no mesmo tipo de equipamentos, aspeto que se tentou mascarar, mas que é causa de dezenas de mortes todos os anos, comprovado pela DGS, podendo muitas delas ser evitadas se se tivessem mantido as certificações de qualidade do ar interior e os planos de manutenção obrigatoriamente executados.
O presidente da APIRAC disse ainda à RTP que “as análises que são agora exigidas, enquanto que antigamente era feito um rastreio por um perito que com alguns produtos, reagentes químicos, podia detetar se havia alguma coisa que chamasse a atenção, fazia-se a análise mais aprofundada, agora não. Quando se faz é logo a análise aprofundada e essa é caríssima porque tem que ter um equipamento muito específico”.
“Desde 2009 que todos os grandes edifícios tinham que estar certificados. Contam-se pelos dedos durante estes anos todos, até agora, os edifícios do Estado que estão certificados. Em termos de hospitais, por exemplo, enquanto os novos obrigatoriamente tiveram que ser certificados, os existentes é capaz de haver um ou dois que têm certificação energética e a tutela nunca atuou sobre estas situações. O que se pretende é aliviar a situação de prevenção e depois é a punição, é o castigo”, disse Fernando Brito à RTP.
De obrigatório a recomendação
Também aqui, o presidente da União de Freguesias de Póvoa de Santa Iria e Forte da Casa considera que a alteração da legislação pode ter tido alguma influência no que aconteceu no concelho com o surto de legionella.
“Eu acho que talvez essa alteração da legislação tenha sido uma das situações que possa ter permitido que isto tenha acontecido. Estamos a falar no campo subjetivo, não tenho provas, o que é um facto é que nós temos uma lei que é muito mais restritiva e controladora da atividade de empresas e obviamente que, à partida, encurta-se o risco de determinado tipo de situações acontecerem”.
“Quando nós temos uma legislação que permite que aquilo que era especialmente obrigatório em determinados campos passe a ser recomendativo, ou, como diz a lei, a obrigação é termos boas práticas ambientais, isto é uma coisa muito vaga. Permite que nas entidades, nas empresas, a gestão de determinadas matérias possa ser feita de uma forma muito mais subjetiva. Agora, nós não podemos dizer em concreto que foi a alteração da lei que originou isto. Mas podemos dizer que se a lei fosse a anterior, talvez o controle sobre estas matérias pudesse ter sido maior”.

“Fontes decorativas potencialmente perigosas”
O surto de legionella em Vila Franca de Xira não foi caso único em Portugal. Um dos mais marcantes aconteceu, no ano 2000, no concelho de Vizela, onde houve vários casos da doença. Onze pessoas ficaram infetadas e o foco de propagação da doença foi, imagine-se, uma fonte decorativa com repuxos, que existia no centro da cidade.
Naquela altura, uma equipa liderada pelo médico epidemiologista, Guilherme Gonçalves, desenvolveu um estudo científico sobre o caso. A água foi analisada e os resultados davam conta de que a infeção tinha sido provocada por um aerossol produzido na fonte.
“Eu nem consegui contar. Tinha centenas de esguichos. Com fotografias noturnas e com a iluminação pública, era possível ver os borrifos, o tal aerossol, que era uma verdadeira nuvem. Aquela fonte criava um nevoeiro naquela praça, que era uma espécie de nevoeiro artificial”.
Para este especialista, a sua opinião pode ser controversa, mas faz questão de frisar que “devíamos banir as fontes decorativas do nosso país. Podem ser muito bonitas mas são basicamente impossíveis de gerir com segurança”.
E dá um exemplo: “A água da torneira que bebemos tem cloro, mata os microorganismos, mata a legionella. Isso é uma das razões pelas quais a água é segura e está na torneira. Ora, se puser água tratada numa fonte decorativa, a fonte é em circuito fechado, portanto, há uma água que circula. Ao fim de duas passagens perdeu o cloro todo, ou seja, aquela água fica não tratada ao fim de uma hora ou duas horas e depois está lá dias e semanas a esguichar”.
Guilherme Gonçalves considera que as fontes decorativas são potencialmente muito perigosas. “A água é um bem que deve ser encarado pelos cidadãos e pelas entidades, como mais valiosa do que o ouro ou do que o petróleo e eu acho que as nossas cidades não precisam de ter essas fontes”.
E foram vários os casos que este epidemiologista, enquanto autoridade de saúde, acompanhou.
“Alguns anos mais tarde estava eu num município que tinha umas festas no verão com muitas pessoas nas ruas. Uns dias antes das festas, enquanto autoridade de saúde, eu fui inspecionar as ruas e havia umas quantas fontes decorativas no trajeto onde iam passar milhares de pessoas. Eu determinei o encerramento de todas as fontes decorativas antes das festas e durante as festas, mas pela legislação não podia determinar o seu encerramento definitivo. Aquela cidade com milhares de pessoas na rua com aqueles borrifos todos, tinha ali uma bomba relógio e eu atirei a bomba fora”, recorda.
962 casos notificados em nove anos
De acordo com a DGS, no período de 2004 a 2013 foram notificados 962 casos de Doença dos Legionários (DL) em Portugal. Destes, 89,6 por cento foram confirmados, sete por cento são casos prováveis e 3,4 por cento casos de classificação desconhecida.
Os números fazem parte do estudo “Vigilância em Saúde Pública”, no período de 2004 a 2013, integrado no programa de vigilância epidemiológica integrada de infeções por legionella, e foi criado em 2004.
“A DL em Portugal é, desde esse ano, alvo de um sistema de vigilância de saúde pública que contempla dois circuitos de informação: os casos de DL notificados pelo circuito de notificação clínica e os casos notificados pelo circuito de notificação laboratorial”, pode ler-se no estudo.
Analisado este período, os casos apresentam uma distribuição assimétrica no território nacional. Nos distritos do Porto, Lisboa e Braga verificaram-se 73 por cento das notificações de DL. É ainda importante referir que não houve qualquer caso notificado de DL na Região Autónoma dos Açores e apenas um na Região Autónoma da Madeira, regiões que registam assim a menor notificação de casos de DL.
Dos 962 casos notificados de DL, 210 (21,8 por cento) foram em indivíduos do sexo feminino e 752 (78,2 por cento) do sexo masculino. Na distribuição dos casos por grupo etário, verifica-se que o maior número de casos ocorreu no grupo etário dos 50 aos 59 anos de idade.
Em relação à distribuição dos casos notificados de DL ao longo do ano, 47,3 por cento iniciaram sintomatologia nos meses de agosto a novembro. Em oposição, nos meses de janeiro a abril, apenas 18,5 por cento dos casos notificados de DL iniciaram sintomas.
No período em análise, 5,9 por cento dos casos notificados resultaram em morte. É de salientar, contudo, que houve uma proporção importante de casos na qual é desconhecida a evolução, sendo em 2009 desconhecida a evolução de mais de metade.
Dos 962 casos notificados de DL, 45 não tiveram registo de qualquer fator de risco individual, 471 apresentaram pelo menos um fator de risco e em 446 era desconhecida a existência ou ausência de fatores de risco individuais.

A sazonalidade dos casos notificados de DL em Portugal é semelhante à que se verifica noutros países europeus, embora em Portugal o pico de casos no verão/outono seja um pouco mais tardio.
Uma possível explicação para este facto poderá ser a existência de temperaturas ainda relativamente elevadas que facilitam a replicação de legionella.
Ao mesmo tempo que se verificam valores de humidade e de precipitação mais elevados no início do outono e parece existir uma associação entre o maior número de casos de DL e a maior precipitação e humidade atmosférica.
Quanto ao caso concreto de Vila Franca de Xira - e com a divulgação dos resultados laboratoriais, em dezembro do ano passado, a apontar para uma relação entre as bactérias recolhidas em doentes para análise e aquelas encontradas numa torre de arrefecimento específica -, o segredo de justiça é ainda a justificação para não serem conhecidos mais desenvolvimento do processo.